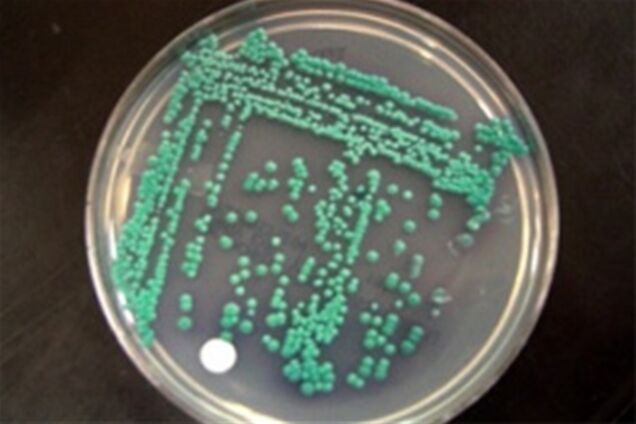
Из дрожжей научились делать пластик
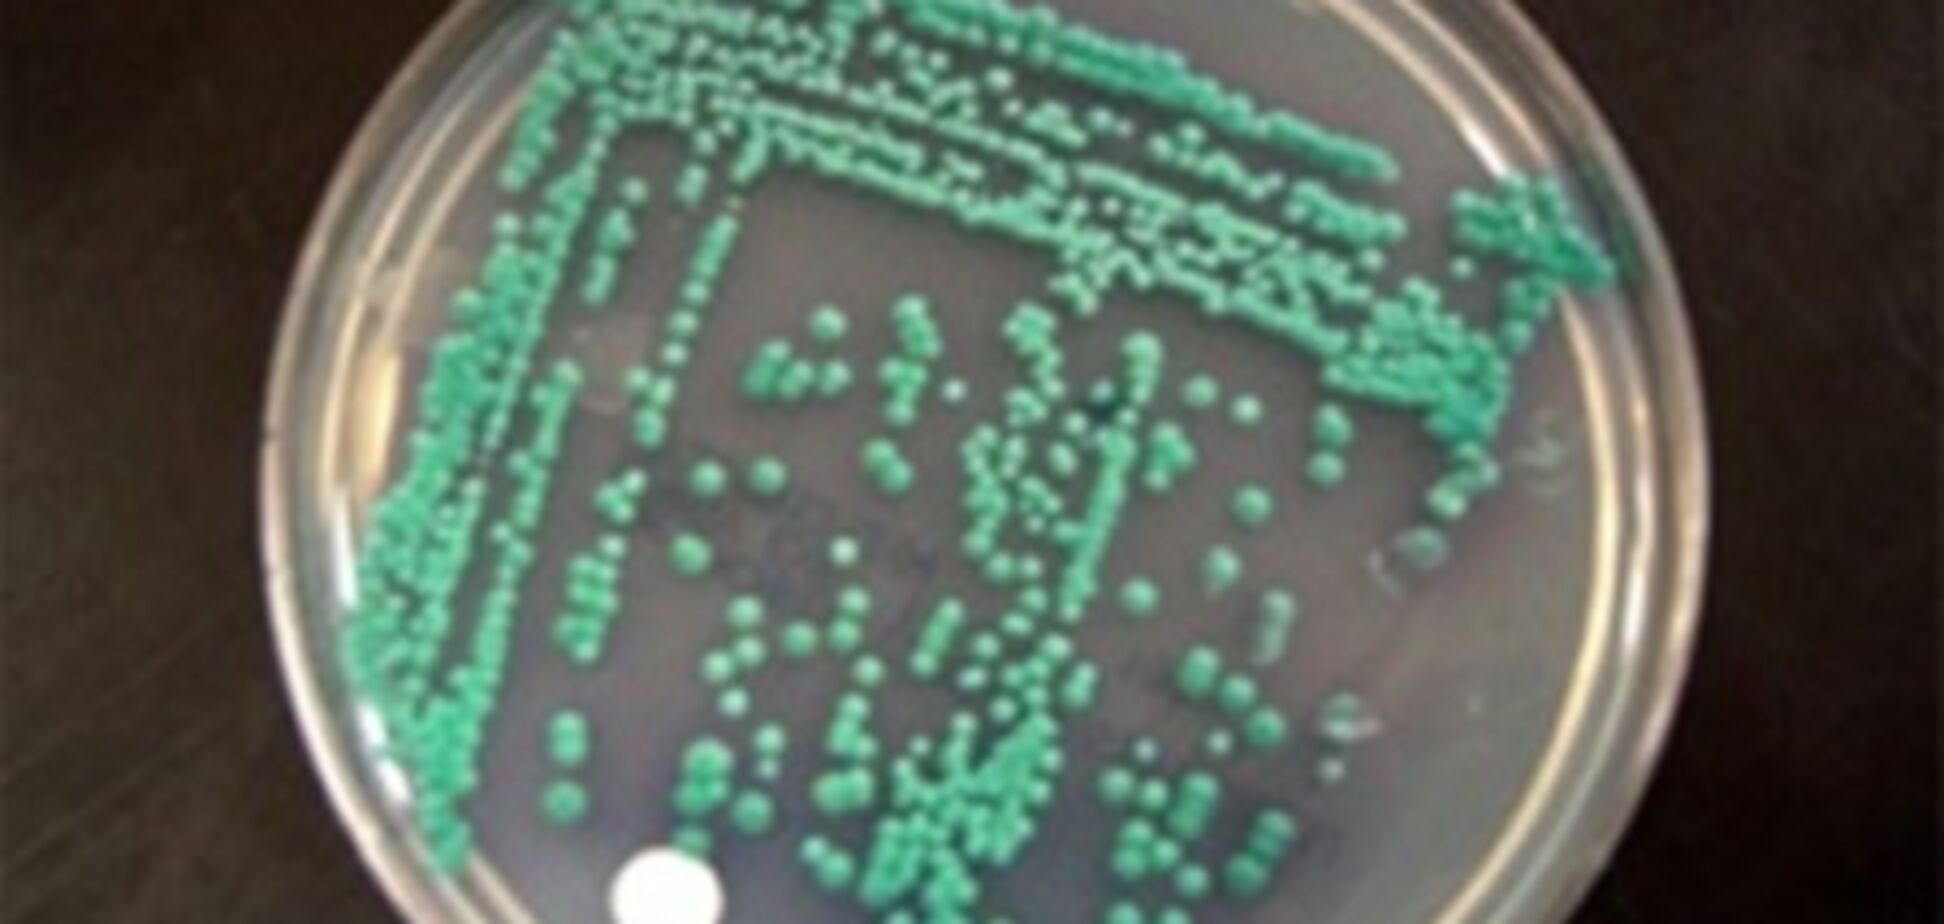
Из дрожжей научились делать пластик

Из дрожжей научились делать пластик
Учёные из Политехнического института Нью-Йоркского университета и калифорнийской компании DNA2.0 Incorporated разработали метод получения биопластика из генетически модифицированного штамма дрожжей Candida tropicalis.
Достигнутые результаты свидетельствуют о возможности создания недорогих, коммерчески жизнеспособных сортов дрожжей, которые могут перерабатывать жирные кислоты в жирные омега-гидроксикислоты — новое семейство мономеров, поддающихся преобразованию в биопластик для самых разных целей.
С использованием традиционных методов эти кислоты сложны и дороги в производстве. Секрет получения нужных дрожжей заключается в устранении определённых ферментов, вызывающих дальнейшее окисление этих веществ в нежелательные дикислоты. Исследователи выявили и устранили 16 генов и другие пути окисления, в результате чего активность преобразования жирных омега-гидроксикислот в дикислоты снизилась на 90%.
Предыдущие исследования показали, что пластмассы на основе схожих материалов обладают солидной прочностью и гибкостью. Их можно будет использовать как ингредиент в смазочных материалах, клеях, косметике, антираковых препаратах. Кроме того, представляется возможным их преобразование в биотопливо, напоминающее биодизель вроде «соевого золота».
В будущем учёные планируют исследовать пути дальнейшей трансформации штамма с целью прямого превращения сырья из триглицеридов в нужную кислоту. Результаты исследования опубликованы в «Журнале Американского химического общества».










